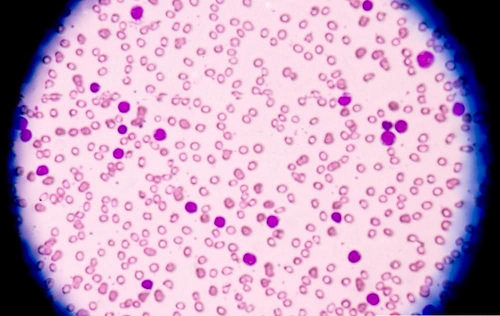

科学家不小心发现一种药物可以让你的白发变黑!
理想情况下,您不会想要治疗的副作用,但实际上总是有风险。 有时候,这些影响是危险的,甚至威胁生命,但偶尔他们可以是奇怪到不行。

据JAMA皮肤病学杂志报道,参与新型杀死癌症临床试验的14名患者在服用新型药物后,已经看到他们的灰白色头发变黑了。
这不是化疗,化疗因为被设计破坏癌细胞,有时会导致头发变薄。 这是一项免疫治疗试验,这是一个新兴的生物医学研究领域,它利用患者自身的机构来打击癌症,从基因治疗开始,或在这种情况下,是一系列新的药物。
这项试验涉及52名肺癌患者。 巴塞隆纳自治大学研究团队给他们Keytruda,Opdivo和Tecentriq的药物,他们不只是想看在某种程度上会不会缓解,还要检查治疗是否有副作用。
这些药物被设计让你的免疫系统成为猎杀癌细胞的工具。 例如,Keytruda阻止称为PD-1的细胞表面受体,通常会阻止白血球破坏人体自身的细胞。

虽然通常是有用的,但这意味着癌细胞可以滑过裂缝并增殖,免疫系统看不见它。 Keytruda等药物使这些不可见的癌细胞再次可见。
在这次试验期间,其中一名患者注意到他们的头发越来越黑,最初被认为是一次性的例外。 然而,当其他13人经历同样的头发染发 (黑色或棕色) ,研究团队知道有些不对劲。

奇怪的是,除了其中一个病人,这些病人对免疫治疗的治疗反应比试验中的其他治疗好得多。 因此,不仅副作用在这种情况下相当正面,而且似乎也表明药物有效。 在这一点上,导致头发颜色变化的机制仍然难以捉摸。
也许更怪的是,过去曾在皮肤癌试验中使用相同的药物,但与头发失色有关。
可悲的是,研究中使用的药物也有很多其他不太好的副作用,所以不能给予健康的人。 然而,这项试验表明,将来可能部署相关药物作为头发染色的可能治疗方法。

发表你的评论吧返回顶部
!评论内容需包含中文
